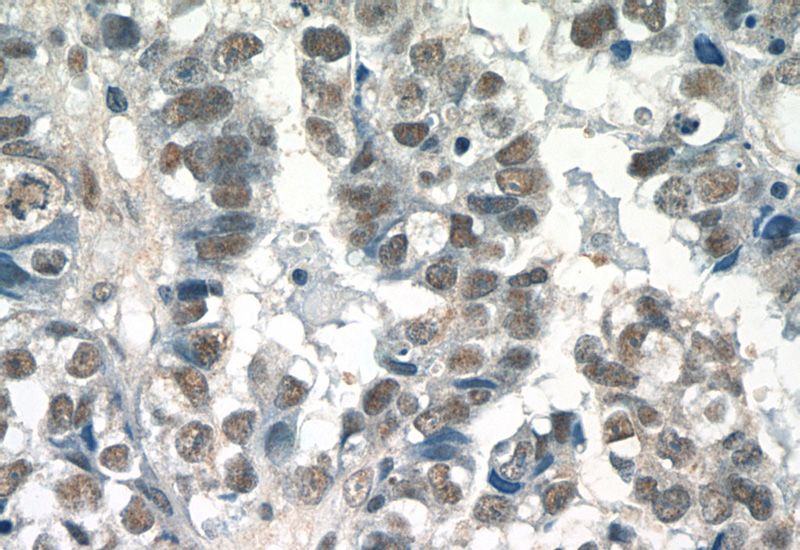
Immunohistochemistry of paraffin-embedded human breast cancer tissue slide using Catalog No:115221(SETD1B Antibody) at dilution of 1:50 (under 40x lens)

-
Product Name
SETD1B antibody
- Documents
-
Description
SETD1B Rabbit Polyclonal antibody. Positive WB detected in human brain tissue, MCF7 cells, mouse liver tissue. Positive IP detected in MCF-7 cells. Positive IHC detected in human breast cancer tissue, human ovary tumor tissue. Observed molecular weight by Western-blot: 250-260 kDa, 450 kDa
-
Tested applications
ELISA, WB, IP, IHC
-
Species reactivity
Human, Mouse; other species not tested.
-
Alternative names
FLJ20803 antibody; hSET1B antibody; KIAA1076 antibody; KMT2G antibody; Lysine N methyltransferase 2G antibody; SET domain containing 1B antibody; Set1B antibody; SETD1B antibody
-
Isotype
Rabbit IgG
-
Preparation
This antibody was obtained by immunization of Peptide (Accession Number: NM_015048). Purification method: Antigen affinity purified.
-
Clonality
Polyclonal
-
Formulation
PBS with 0.02% sodium azide and 50% glycerol pH 7.3.
-
Storage instructions
Store at -20℃. DO NOT ALIQUOT
-
Applications
Recommended Dilution:
WB: 1:200-1:2000
IP: 1:200-1:1000
IHC: 1:20-1:200
-
Validations

human brain tissue were subjected to SDS PAGE followed by western blot with Catalog No:115221(SETD1B antibody) at dilution of 1:800

IP Result of anti-SETD1B (IP:Catalog No:115221, 5ug; Detection:Catalog No:115221 1:300) with MCF-7 cells lysate 3250ug.
Immunohistochemistry of paraffin-embedded human breast cancer tissue slide using Catalog No:115221(SETD1B Antibody) at dilution of 1:50 (under 40x lens)

Immunohistochemistry of paraffin-embedded human ovary tumor tissue slide using Catalog No:115221(SETD1B Antibody) at dilution of 1:50 (under 40x lens)
-
Background
SETD1B, also named as KMT2G. Set1B associates with a about 450 kDa complex that contains all five non-catalytic components of the Set1A complex, including CFP1, Rbbp5, Ash2, Wdr5, and Wdr82. The complex is a histone methyltransferase that produces trimethylated histone H3 at Lys4. Set1B is widely expressed, and localize to a largely non-overlapping set of euchromatic nuclear speckles, suggesting that Set1B bind to a unique set of target genes and thus make non-redundant contributions to the epigenetic control of chromatin structure and gene expression( PMID: 17355966). The antibody is specific to SETD1B and, in westernbloting experiments, two specific bands can be detected, about 250 kDa, 450 kDa respectively, in addition, a unknown band around 70 kDa. This antibody is a rabbit polyclonal antibody raised against a region of human SETD1B.
Related Products / Services
Please note: All products are "FOR RESEARCH USE ONLY AND ARE NOT INTENDED FOR DIAGNOSTIC OR THERAPEUTIC USE"
